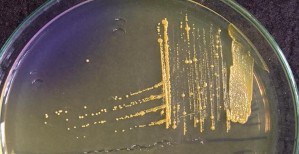
a Hình 4 1 Khuẩn lạc dòng vi khuẩn phân lập trên môi trường TYEG agar có bổ sung 1
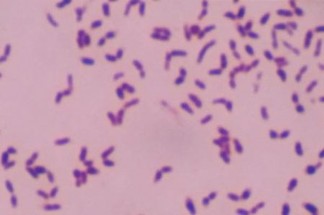
Hình 4 2 Hình thái tế bào vi khuẩn P acnes dưới kính hiển vi 4 1 2 2 Kết quả 3
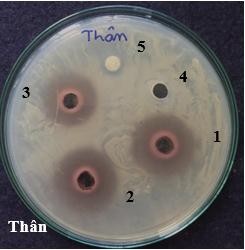
Hình 4 7 Khả năng ức chế vi khuẩn P acnes của cao chiết ethanol các bộ phân cây 8
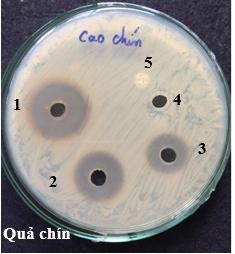
Hình 4 7 Khả năng ức chế vi khuẩn P acnes của cao chiết ethanol các bộ phân cây 9
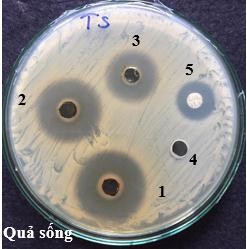
Hình 4 7 Khả năng ức chế vi khuẩn P acnes của cao chiết ethanol các bộ phân cây 10
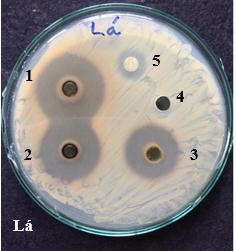
Hình 4 7 Khả năng ức chế vi khuẩn P acnes của cao chiết ethanol các bộ phân cây 11
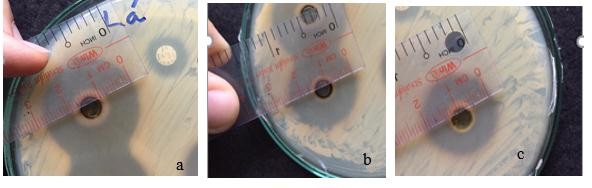
Hình 4 8 Vòng vô khuẩn của cao chiết ethanol lá Trứng cá ức chế vi khuẩn P acnes 12

3.4. PHƯƠNG PHÁP XỬ LÝ SỐ LIỆU
Các số liệu thí nghiệm được xử lý và phân tích thống kê bằng phần mềm SPSS Satistics 20, phân tích ANOVA với độ tin cậy 95 %, các giá trị trung bình được so sánh bằng Duncan, các thí nghiệm được lặp lại 3 lần.
3.5. SƠ ĐỒ NGHIÊN CỨU
Sơ đồ bố trí tổng quát thí nghiệm được trình bày trong hình 3.4
Bộ phận cây Trứng cá
Nuôi cấy/ TYEG agar
Vi khuẩnP. acnes
Đun hồi lưu Ethanol 96 % trong 3
giờ ở 70 oC Dịch chiết
Bốc hơi trên bếp cách thủy
Cao chiết
Nhận diện
Kháng khuẩn
Định tính bộ phận kháng
khuẩn cao nhất
Hình 3.4. Sơ đồ bố trí tổng quát thí nghiệm
3.6. BIỆN PHÁP KHẮC PHỤC SAI SỐ
- Đưa ra các tiêu chí chọn mẫu.
- Hiệu chỉnh các thiết bị trước khi sử dụng
- Sử dụng các thiết bị độ chính xác cao
- Các thí nghiệm được lặp lại 3 lần và lấy kết quả trung bình
CHƯƠNG 4: KẾT QUẢ VÀ THẢO LUẬN
4.1. KẾT QUẢ
4.1.1. Chiết cao
Sử dụng phương pháp chiết nóng đun hồi lưu và dung môi ethanol 96 % thu được các loại cao chiết với kết quả thể hiện như sau
Bảng 4.1. Kết quả độ ẩm cao cây Trứng cá
Độ ẩm (%) | Độ ẩm cao (%) | |
Lá Vỏ thân Quả chín Quả non | 12,8 13,0 - - | 17,38 15,00 19,05 18,82 |
Có thể bạn quan tâm!
-
Cơ Chế Gây Bệnh Trứng Cá Vi Khuẩn Propionibacterium Acnes -
Tình Hình Nghiên Cứu Và Ứng Dụng Cao Chiết Từ Cây Trứng Cá Trong Và Ngoài Nước -
Nuôi Cấy Và Nhận Diện Dòng Vi Khuẩn Propionibacterium Acnes -
Định Tính Một Số Hợp Chất Thiên Nhiên Trong Cao Chiết Từ Lá Trứng Cá -
Khảo sát khả năng ức chế vi khuẩn gây bệnh mụn trứng cá Propionibacterium acnes của cao chiết từ cây Trứng cá Muntingia calabura L. - 8 -
Khảo sát khả năng ức chế vi khuẩn gây bệnh mụn trứng cá Propionibacterium acnes của cao chiết từ cây Trứng cá Muntingia calabura L. - 9
Xem toàn bộ 89 trang tài liệu này.
Nhận xét: độ ẩm nguyên liệu khô lá và vỏ thân cây Trứng cá dưới 13 % đạt theo mô tả độ ẩm dược liệu theo DĐVN IV. Độ ẩm trung bình của cao ở các bộ phân đều không quá 20 %, cao thu được ở dạng cao đặc theo PL1.1 DĐVN IV. Độ ẩm trong cao quả, chín là cao nhất trong bốn loại cao khảo sát (19,05 %).
Bảng 4.2. Kết quả hiệu suất chiết cao từ cây Trứng cá
Khối lượng khô (g) | Khối lượng tươi (g) | Khối lượng cao toàn phần (g) | Hiệu suất chiết (%) | |
Lá Vỏ thân Quả chín Quả non | 207,75 212,65 - - | - - 300 300 | 90,04 70,74 102,16 74,45 | 43,34 33,27 34,05 24,82 |
Nhận xét: khối lượng cao thu được cao nhất là ở quả chín (102,16 g) hiệu suất chiết các lá, vỏ thân, quả non và quả chín với dung môi ethanol 96 % bằng phương pháp đun hồi lưu lần lượt là 43,34 %; 33,27 %; 34,05 % và 24,82 % (so với khối lượng khô). Hiệu suất chiết cao từ lá Trứng cá cao nhất trong bốn loại cao (43,34 %)
4.1.2. Nuôi cấy và nhận diện vi khuẩn Propionibacterium acnes
4.1.2.1. Kết quả đặc điểm hình thái của dòng vi khuẩn nuôi cấy
Đặc điểm khuẩn lạc
Quan sát khuẩn lạc của dòng vi khuẩn 134N trên môi trường TYEG agar có bổ sung 0,002 % bromocresol purple cho thấy: dòng vi khuẩn sinh trưởng chậm, khuẩn lạc xuất hiện rõ sau 5 - 7 ngày nuôi cấy, kích thước khuẩn lạc nhỏ. Dòng vi khuẩn 134N có màu vàng đậm, tròn, mô cao hoàn toàn trên bề mặt môi trường, bìa nguyên.
Hình dạng khuẩn lạc: hình tròn, mô cao hoàn toàn trên bề mặt môi trường, bìa nguyên. Màu sắc khuẩn lạc: khuẩn lạc của dòng vi khuẩn 134N trên môi trường TYEG agar có bổ sung bromocresol purple đều có màu vàng nhạt đến đậm.
Kích thước khuẩn lạc: đường kính khuẩn lạc của dòng vi khuẩn 134N có kích thước dao động 0,8 - 1,3 mm sau 5 - 7 ngày nuôi cấy.
a
Hình 4.1. Khuẩn lạc dòng vi khuẩn phân lập trên môi trường TYEG agar có bổ sung 0,002 % bromocresol purple.
a. Dòng vi khuẩn 134N màu vàng đậm
b. Dòng vi khuẩn 134N chụp nghiêng
Đặc điểm tế bào vi khuẩn
Quan sát hình thái của các tế bào vi khuẩn dưới kính hiển vi quang học ở vật kính 100X (độ phóng đại 1000 lần) cho thấy dòng vi khuẩn có dạng que ngắn.
Hình 4.2. Hình thái tế bào vi khuẩn P. acnes dưới kính hiển vi
4.1.2.2. Kết quả đặc điểm sinh hoá dòng vi khuẩn nuôi cấy
Dòng vi khuẩn 134N thuộc vi khuẩn Gram dương (bắt màu tím xanh của crystal violet), catalase dương tính (khuẩn lạc làm sủi bọt H2O2 3 %)

Hình 4.3. Thử nghiệm catalase trên dòng vi khuẩn phân lập
Dòng vi khuẩn 134N được nuôi trong ống nghiệm chứa môi trường trypticase soyar borth trong 24 giờ ở 37 oC, sau đó kiểm tra khả năng sinh indol bằng thuốc thử Kovac’s. Kết quả thí nghiệm cho thấy, dòng vi khuẩn tạo được indol từ môi trường nuôi cấy chứa trytophan vì làm biến đổi màu thuốc thử Kovac’s từ vàng sang đỏ. Trong khi dòng đối chứng Staphylococcus aureus không có khả năng này.

Hình 4.4. Kiểm tra khả năng sinh indol trên dòng vi khuẩn
a. Dòng vi khuẩn 134N tạo indol
b. Đối chứng không tạo indol
Dòng vi khuẩn 134N được nuôi trong ống nghiệm chứa môi trường pepton và KNO3 ở 37 oC, sau đó kiểm tra khả năng phản nitrat hóa. Kết quả thí nghiệm cho thấy, dòng vi khuẩn phân lập có khả năng khử NO3- môi trường sinh khí NH3 và vẫn phát triển bình thường.

Hình 4.5. Kiểm tra khả năng phản nitrat hóa trên dòng vi khuẩn phân lập
a. Dòng vi khuẩn 134N tạo phản ứng phản nitrat hóa
b. Đối chứng âm
Quan sát khả năng làm dịch hoá gelatin tại nhiệt độ phòng từ 20 oC trở xuống. Dòng vi khuẩn 134N làm một phần bề mặt môi trường gelatin hoá lỏng lõm xuống phản ứng dương tính, đối chứng âm môi trường gelatin không chứa dòng vi khuẩn 134N.

Hình 4.6. Kiểm tra khả năng làm dịch hóa gelatin trên dòng vi khuẩn 134N
a. Dòng vi khuẩn 134N làm dịch hóa gelatin
b. Đối chứng âm
4.1.3. Khảo sát khả năng ức chế vi khuẩn Propionibacterium acnes của cao chiết cây Trứng cá.
Khả năng ức chế vi khuẩn của cao chiết ethanol lá, vỏ thân, quả chín và quả non cây Trứng cá chiết bằng dung môi ethanol được xác định dựa trên khả năng ức chế sự phát triển của vi khuẩn, thể hiện qua kích thước khoảng vô khuẩn được trình bày bảng 4.3. Hiệu quả kháng khuẩn của các loại cao được khảo sát ở các nồng độ 200 mg/ml; 100 mg/ml; 50 mg/ml bằng phương pháp khuếch tán giếng thạch. Kết quả cho thấy các loại cao lá, vỏ thân, quả chín và quả non cây Trứng cá có khả năng ức chế dòng vi khuẩn P. acnes.
Loại cao
Đường kính vòng vô khuẩn (mm)
Nồng độ cao chiết bằng ethanol (mg/ml)
Đối chứng
dương
Bảng 4.3. Khả năng ức chế vi khuẩn P. acnes của các loại cao cây trứng cá bằng phương pháp khuếch tán trên giếng thạch.
50 | 100 | 200 DMSO | Levofloxacin | ||
Vỏ thân | 10,33 ± 0,577a | 11,67 ± 1,155a | 16,67 ± 2,309a | 0 | 0 |
Quả chín | 11 ± 0,000a | 13,33 ± 1,528a | 20 ± 1,000a | 0 | 0 |
Quả non | 11,67 ± 0,577b | 18 ± 1,000b | 20,67 ± 1,155b | 0 | 8,67 ± 0,577b |
Lá | 16,33 ± 2,082c | 19 ± 0,000b | 23 ± 1,732b | 0 | 8,67 ± 0,577b |
p | 0,032 | 0,000 | 0,010 | 0,000 |
Ghi chú: số liệu đường kính vô khuẩn là giá trị trung bình của 3 lần lặp lại. Trong cùng một cột, có số liệu có ít nhất 1 chữ cái theo sau giống nhau thì không khác biệt ở ý nghĩa 5%. Đối chứng (-): DMSO cho đường kính kháng khuẩn bằng 0.

Hình 4.7. Khả năng ức chế vi khuẩn P. acnes của cao chiết ethanol các bộ phân cây Trứng cá ở nồng độ 200 mg/ml; 100 mg/ml; và 50 mg/ml.
Ghi chú: (1) nồng độ 200 mg/ml; (2) nồng độ 100 mg/ml; (3) nồng độ 50 mg/ml;
(4) đối chứng âm DMSO; (5) đối chứng dương levofloxacin
Hình 4.8. Vòng vô khuẩn của cao chiết ethanol lá Trứng cá ức chế vi khuẩn P. acnes ở nồng độ 200 mg/ml; 100 mg/ml và 50 mg/ml
a. Nồng độ cao chiết từ lá Trứng cá 200 mg/ml
b. Nồng độ cao chiết từ lá Trứng cá 100 mg/ml
c. Nồng độ cao chiết từ lá Trứng cá 50 mg/ml
Nhận xét: qua kết quả thí nghiệm ở bảng 4.3 cho thấy cao Trứng cá chiết bằng dung môi ethanol 96 % ở các nồng độ 200 mg/ml; 100 mg/ml và 50 mg/ml đều có khả năng ức chế dòng vi khuẩn 134N với kích thước khoảng vô khuẩn dao động từ 10,33 mm đến 23 mm. Các nồng độ cao Trứng cá đều có khoảng vô khuẩn lớn hơn so với kháng sinh đối chứng levofloxacin, cho thấy khả năng ức chế dòng vi khuẩn 134N của cao Trứng cá chiết bằng dung môi ethanol 96 % cao hơn kháng sinh đối chứng.. Khi so sánh giữa các nồng độ, ở nồng độ 200 mg/ml tạo khoảng vô khuẩn cao nhất trong 3 nồng độ khảo sát đạt giá trị 16,67 ± 2,309 mm ở vỏ thân, 20 ± 1,000 mm ở trái chín, 20,67 ± 1,155 mm ở trái non và 23 ± 1,732 mm ở lá (mức ý nghĩa p = 0,032). Ở nồng độ 200 mg/ml cao Trứng cá chiết bằng dung môi ethanol 96% tạo khoảng vô khuẩn trên dòng P. acnes 134N từ 16,67 mm đến 23 mm trong đó ức chế mạnh nhất ở cao chiết lá (khoảng vô khuẩn 23 mm) kế đến là trái non, trái chín và vỏ thân. Ở nồng độ 100 mg/ml, cao lá cho khoảng vô khuẩn lớn nhất 19 ± 0,000 mm. Ở nồng độ 50 mg/ml, cao lá cho khoảng vô khuẩn lớn nhất 16,33 ± 2,082 mm. Kết quả phân tích cho thấy cao lá Trứng cá ở các nồng độ 200 mg/ml; 100 mg/ml; 50 mg/ml hiệu quả ức chế dòng vi khuẩn 134N cao nhất, kích thước khoảng vô khuẩn trung bình ở từng nồng độ 200 mg/ml; 100 mg/ml; 50 mg/ml cao lá lần lượt là 23 ± 1,732 mm; 19 ± 0,000 mm; 16,33 ± 2,082mm. Từ đó sử dụng cao lá cho các thí nghiệm tiếp theo tìm MIC và định tính một số hợp chất thiên nhiên có hoạt tính sinh học trong cao lá Trứng cá.
4.1.4 Xác định nồng độ ức chế tối thiểu của cao lá cây Trứng cá trên vi khuẩn
Propionibacterium acnes
Dựa trên kết quả thí nghiệm trên, cao chiết từ lá Trứng cá được chọn để xác định nồng độ ức chế tối thiểu (MIC) vi khuẩn P. acnes và nồng độ được khảo sát lần lượt là 40 mg/ml; 20 mg/ml; 10 mg/ml và 5 mg/ml. Đối chứng sử dụng: đối chứng âm






